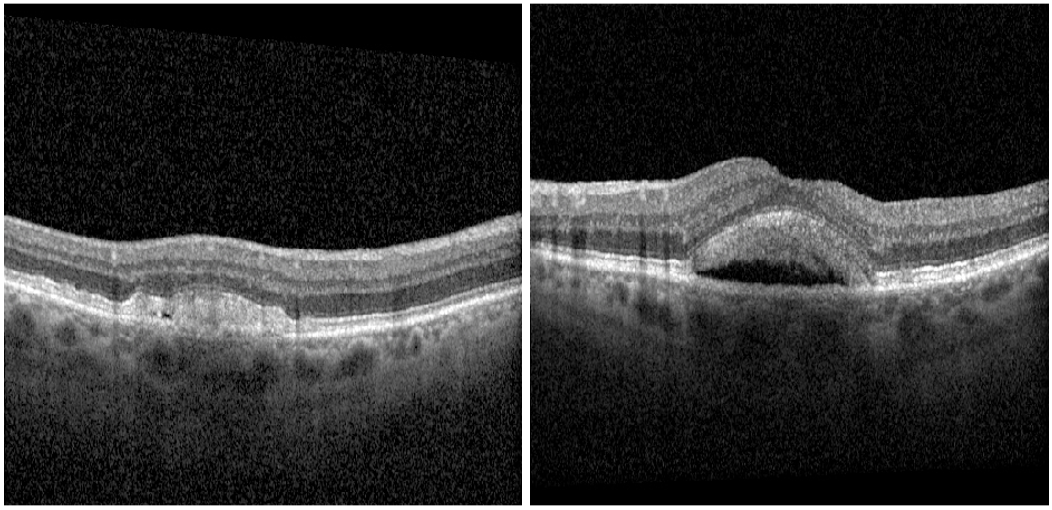

Adult-onset Foveomacular Vitelliform Dystrophy as a Masquerader of Wet Macular Degeneration
Betty Zhang, O.D. Retina Optometrist
Murtaza Adam, M.D. Retina Specialist
An 81-year-old white male presented with a complaint of gradual distortion in their central vision. The patient’s referring ophthalmologist noted a concern for neovascular age-related macular degeneration. The patient’s visual acuity was 20/30 OD and 20/25 OS. OCT of the right eye showed RPE elevation consistent with drusen and highly reflective, subretinal lesion. OCT of the left eye demonstrated a larger, highly reflective and well-circumscribed, homogenous subretinal (pseudo-vitelliform) lesion with an underlying optically empty zone. Fundus autofluorescence (FAF) imaging disclosed hyperfluorescence corresponding to the areas of RPE irreuglarities and pseudovitelliform lesions in both eyes. Fluorescein angiography (FA) was performed to differentiate the optically empty zone from subretinal fluid associated with a choroidal neovascular membrane (CNVM). FA showed macular staining consistent with drusen and no hyperfluorescence consistent with leakage, indicating the absence of a CNVM. The patient was diagnosed with adult onset foveomacular vitelliform dystrophy with a plan to observe every six months.

Adult-onset vitelliform dystrophy generally onsets between the fourth and sixth decade. The disease course is slowly progressive but can result in significant vision decline in cases with development of CNVM or macular atrophy.1 Patients present with subretinal, well-circumscribed lesions that appear yellow on macular examination. Fundus autofluorescence shows increased autofluorescence corresponding to the lesion, and OCT reveals hyperreflective material between the ellipsoid zone and the retinal pigment epithelium. In later stages, the pseudovitellifom lesion may resorb, resulting in an optically empty zone within the pseudovitelliform lesion, reduction in size of lesion, and eventually RPE atrophy.2 The optically empty zone can resemble subretinal fluid, masquerading as wet macular degeneration. FA may be required to differentiate between CNVM and resorption of vitelliform lesion. Patients with pseudovitelliform lesions that present concurrently with subretinal drusenoid deposits may be at a higher risk of developing CNVM and/or macular atrophy.1
References:
- Wilde, C., Awad, M., Giannouladis, K. et al. Natural course of adult-onset vitelliform lesions in eyes with and without comorbid subretinal drusenoid deposits. Int Ophthalmol 40, 1501–1508 (2020). https://doi.org/10.1007/s10792-020-01319-2
- Querques, G., Forte, R., Querques, L., Massamba, N., & Souied, E. H. (2011). Natural Course of Adult-Onset Foveomacular Vitelliform Dystrophy: A Spectral-Domain Optical Coherence Tomography Analysis. American Journal of Ophthalmology, 152(2), 304–313. doi:10.1016/j.ajo.2011.01.047
